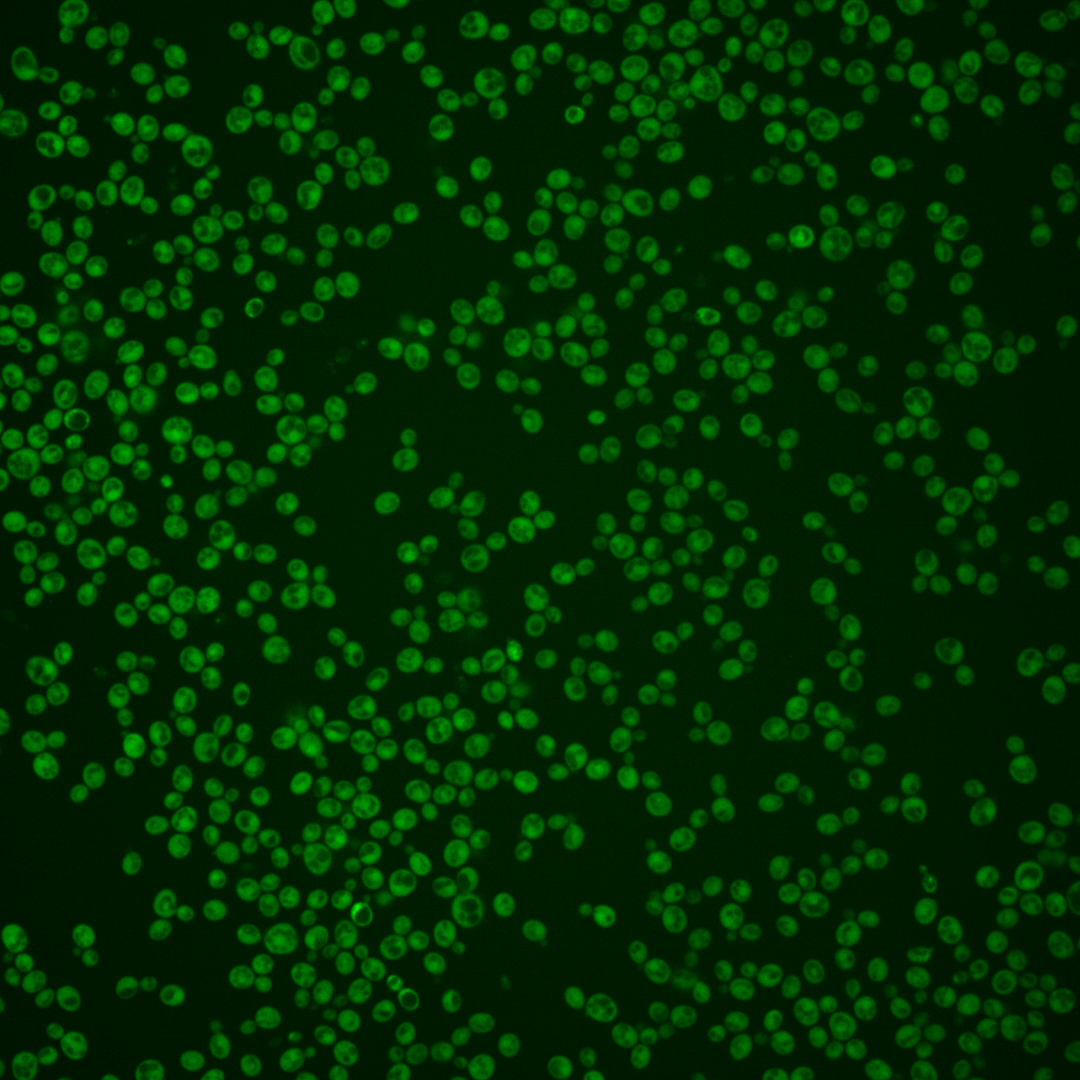
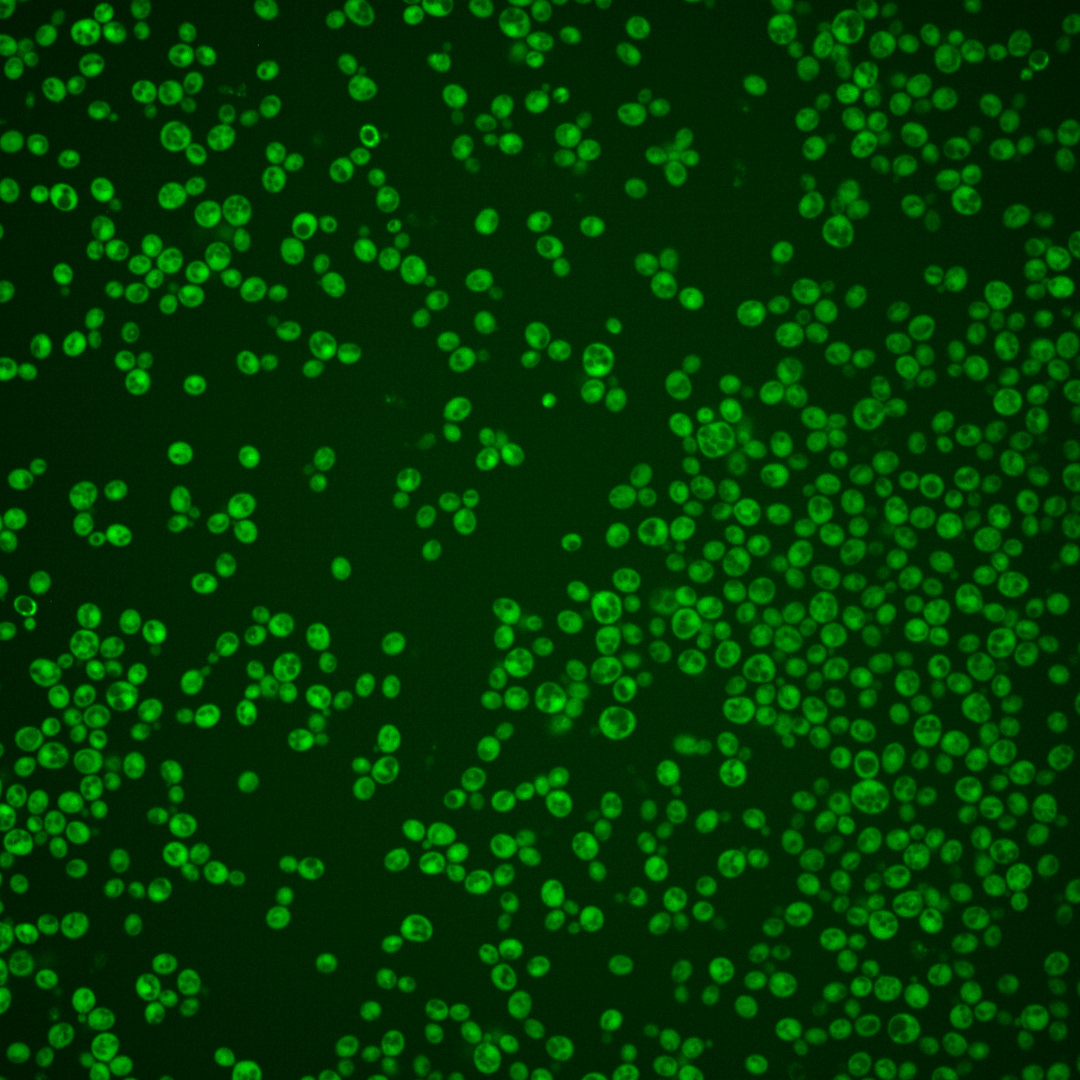
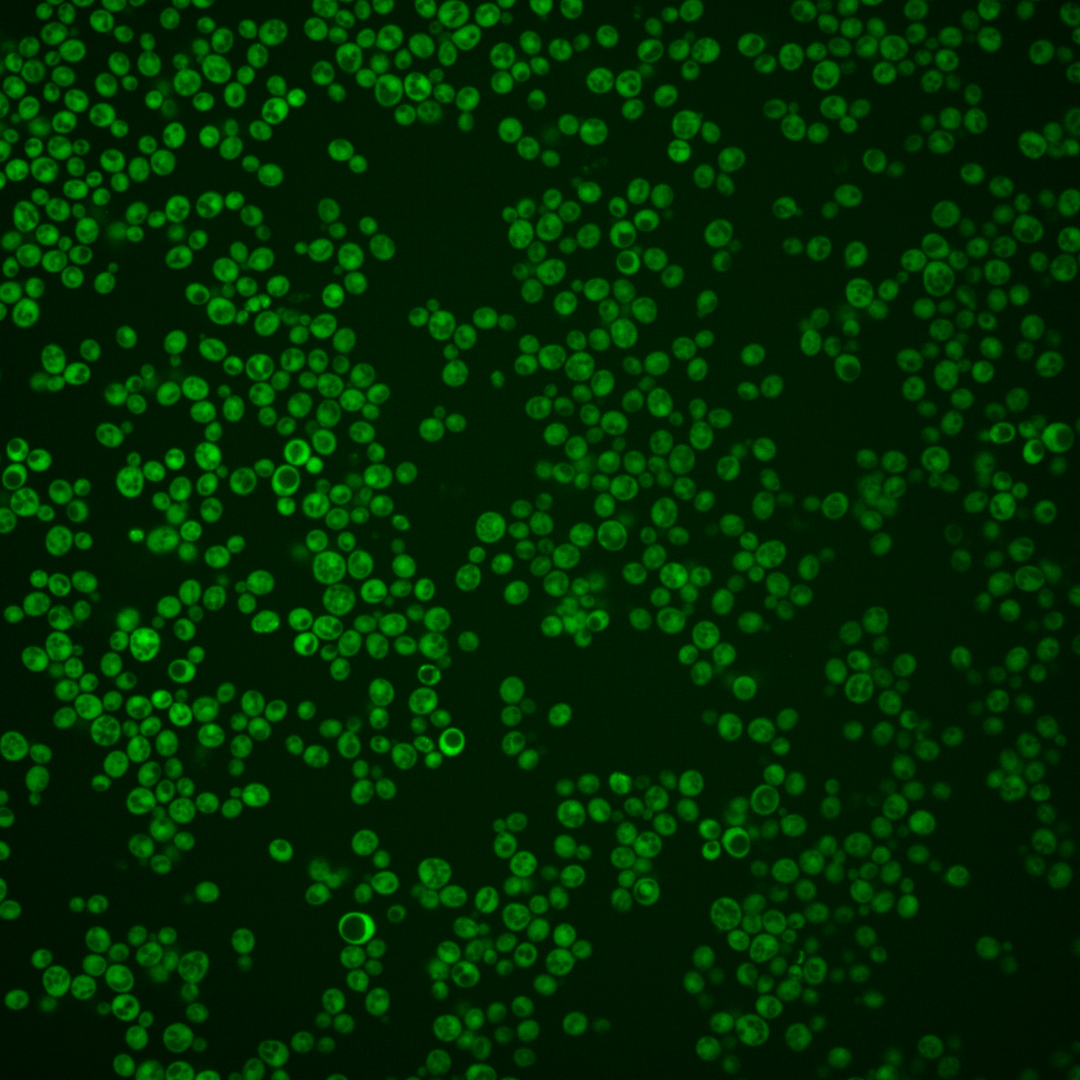
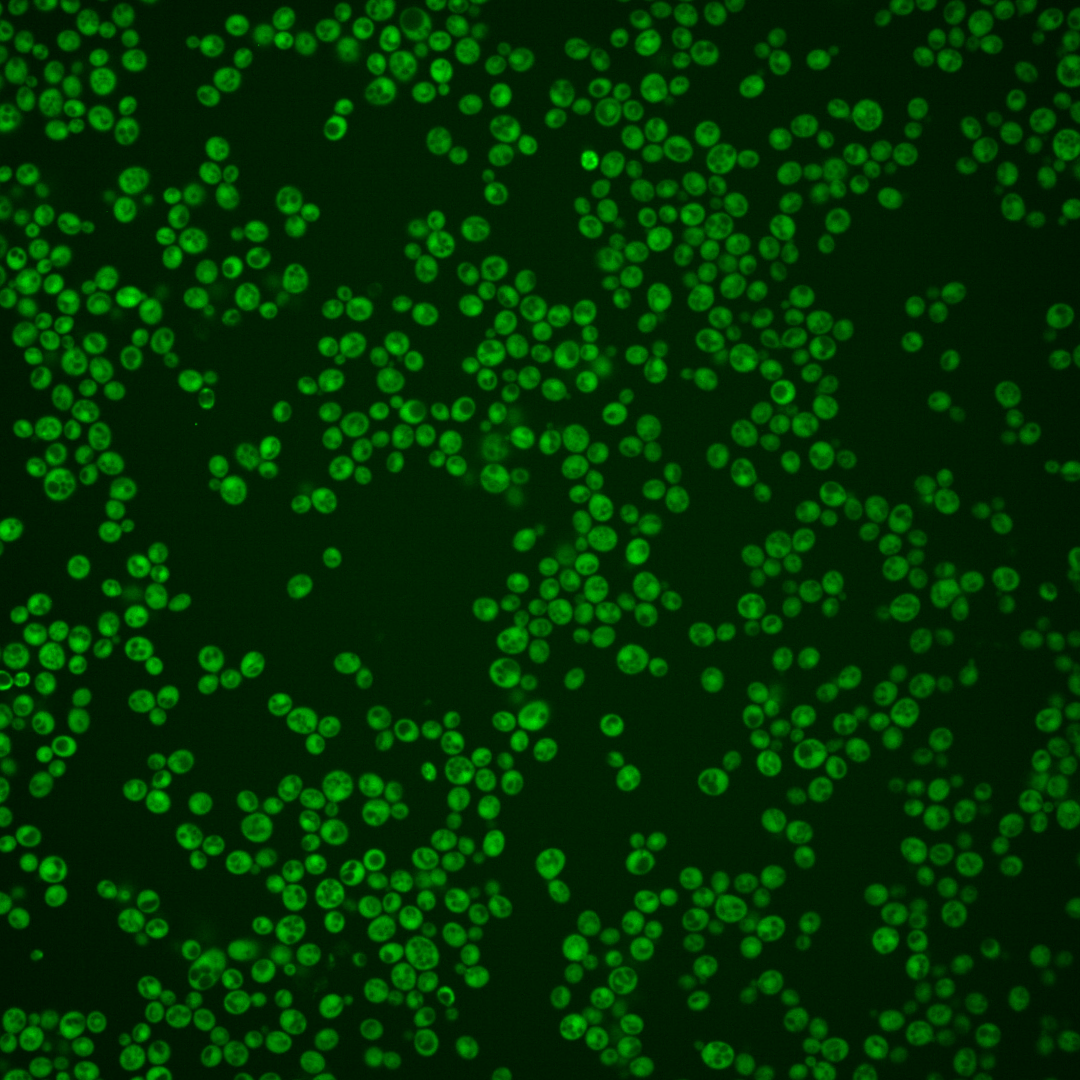

| Standard name | |
|---|---|
| Human Ortholog | |
| Description | Coproporphyrinogen III oxidase; oxygen-requiring enzyme that catalyzes sixth step in heme biosynthetic pathway; transcription is repressed by oxygen and heme (via Rox1p and Hap1p); human homolog CPOX can complement yeast mutant and allow growth of haploid null after sporulation of a heterozygous diploid |
Micrographs




















































































Sub-cellular Localization
Yeast GFP Assignment
Protein Abundance
Localization Change
External localization resources
| ensLOC | DeepLoc | |||||||||||||||||||||||
|---|---|---|---|---|---|---|---|---|---|---|---|---|---|---|---|---|---|---|---|---|---|---|---|---|
| Localization | WT1 | WT2 | WT3 | RAP60 | RAP140 | RAP220 | RAP300 | RAP380 | RAP460 | RAP540 | RAP620 | RAP700 | HU80 | HU120 | HU160 | rpd3Δ_1 | rpd3Δ_2 | rpd3Δ_3 | WT1 | WT2 | WT3 | AF100 | AF140 | AF180 |
| Cortical Patches | 0 | 0 | 0 | 0 | 0 | 0 | 0 | 0 | 0 | 0 | 1 | 1 | 0 | 0 | 0 | 1 | 0 | 0 | 1 | 0 | 0 | 0 | 0 | 1 |
| Bud | 0 | 0 | 0 | 0 | 1 | 1 | 2 | 3 | 3 | 2 | 2 | 6 | 0 | 1 | 1 | 0 | 0 | 0 | 0 | 1 | 0 | 0 | 0 | 5 |
| Bud Neck | 0 | 0 | 0 | 0 | 0 | 0 | 0 | 0 | 0 | 0 | 0 | 0 | 0 | 0 | 0 | 0 | 0 | 0 | 0 | 0 | 0 | 0 | 0 | 0 |
| Bud Site | 0 | 0 | 0 | 0 | 0 | 0 | 0 | 0 | 0 | 0 | 0 | 0 | 0 | 0 | 0 | 0 | 0 | 0 | – | – | – | – | – | – |
| Cell Periphery | 1 | 0 | 0 | 0 | 2 | 6 | 9 | 2 | 3 | 9 | 5 | 7 | 0 | 2 | 0 | 7 | 10 | 7 | 0 | 0 | 0 | 0 | 0 | 0 |
| Cytoplasm | 287 | 86 | 50 | 227 | 335 | 230 | 289 | 297 | 184 | 193 | 211 | 216 | 218 | 370 | 414 | 189 | 136 | 179 | 284 | 83 | 95 | 176 | 306 | 365 |
| Endoplasmic Reticulum | 1 | 1 | 1 | 0 | 1 | 0 | 1 | 7 | 9 | 8 | 1 | 9 | 0 | 0 | 0 | 7 | 4 | 7 | 0 | 1 | 0 | 0 | 0 | 0 |
| Endosome | 0 | 0 | 0 | 0 | 0 | 1 | 0 | 1 | 0 | 0 | 0 | 0 | 0 | 0 | 0 | 2 | 1 | 0 | 1 | 0 | 0 | 0 | 0 | 1 |
| Golgi | 1 | 1 | 0 | 0 | 1 | 0 | 0 | 1 | 0 | 0 | 0 | 0 | 0 | 0 | 0 | 0 | 0 | 1 | 2 | 0 | 0 | 0 | 0 | 0 |
| Mitochondria | 7 | 1 | 1 | 2 | 7 | 11 | 24 | 32 | 46 | 27 | 51 | 32 | 0 | 0 | 0 | 1 | 2 | 2 | 0 | 2 | 0 | 0 | 0 | 0 |
| Nucleus | 0 | 0 | 0 | 1 | 0 | 0 | 6 | 10 | 6 | 7 | 5 | 8 | 1 | 1 | 1 | 4 | 4 | 1 | 0 | 0 | 0 | 0 | 0 | 0 |
| Nuclear Periphery | 1 | 0 | 0 | 0 | 0 | 0 | 0 | 0 | 1 | 3 | 0 | 0 | 0 | 0 | 0 | 0 | 0 | 0 | 0 | 0 | 0 | 0 | 0 | 1 |
| Nucleolus | 0 | 0 | 0 | 0 | 0 | 0 | 0 | 0 | 1 | 0 | 0 | 2 | 0 | 0 | 0 | 0 | 1 | 0 | 0 | 0 | 0 | 1 | 0 | 1 |
| Peroxisomes | 0 | 0 | 0 | 0 | 0 | 0 | 0 | 0 | 0 | 0 | 0 | 0 | 0 | 0 | 0 | 0 | 0 | 0 | 0 | 0 | 0 | 0 | 0 | 0 |
| SpindlePole | 0 | 0 | 0 | 0 | 0 | 1 | 0 | 0 | 0 | 0 | 0 | 1 | 0 | 0 | 0 | 0 | 0 | 0 | 0 | 1 | 0 | 0 | 1 | 1 |
| Vac/Vac Membrane | 3 | 0 | 0 | 9 | 19 | 49 | 67 | 56 | 27 | 69 | 24 | 49 | 2 | 1 | 1 | 14 | 11 | 6 | 0 | 0 | 0 | 1 | 1 | 0 |
| Unique Cell Count | 296 | 88 | 51 | 233 | 353 | 278 | 365 | 388 | 253 | 285 | 270 | 303 | 220 | 371 | 416 | 204 | 152 | 189 | 296 | 94 | 101 | 185 | 317 | 389 |
| Labelled Cell Count | 301 | 89 | 52 | 239 | 366 | 299 | 398 | 409 | 280 | 318 | 300 | 331 | 221 | 375 | 417 | 225 | 169 | 203 | 296 | 94 | 101 | 185 | 317 | 389 |
Yeast GFP Assignment
Protein Abundance
| Screen | WT1 | WT2 | WT3 | RAP60 | RAP140 | RAP220 | RAP300 | RAP380 | RAP460 | RAP540 | RAP620 | RAP700 | HU80 | HU120 | HU160 | rpd3Δ_1 | rpd3Δ_2 | rpd3Δ_3 | AF100 | AF140 | AF180 |
|---|---|---|---|---|---|---|---|---|---|---|---|---|---|---|---|---|---|---|---|---|---|
| Mean Cell GFP Intensity (1e-4) | 6.5 | 6.8 | 6.0 | 7.2 | 8.0 | 8.5 | 8.0 | 8.5 | 7.4 | 8.2 | 7.4 | 8.4 | 8.3 | 7.8 | 7.9 | 11.1 | 12.6 | 12.7 | 7.4 | 7.5 | 7.5 |
| Std Deviation (1e-4) | 3.1 | 1.3 | 0.9 | 1.4 | 1.3 | 2.1 | 1.7 | 1.8 | 1.7 | 1.8 | 1.7 | 1.8 | 1.3 | 1.1 | 1.3 | 2.0 | 2.4 | 2.3 | 2.4 | 1.2 | 1.7 |
| Intensity Change (Log2) | – | – | – | 0.27 | 0.42 | 0.51 | 0.43 | 0.51 | 0.31 | 0.47 | 0.31 | 0.49 | 0.48 | 0.39 | 0.41 | 0.9 | 1.09 | 1.09 | 0.32 | 0.33 | 0.33 |
Localization Change
| Localization | RAP60 | RAP140 | RAP220 | RAP300 | RAP380 | RAP460 | RAP540 | RAP620 | RAP700 | HU80 | HU120 | HU160 | rpd3Δ_1 | rpd3Δ_2 | rpd3Δ_3 |
|---|---|---|---|---|---|---|---|---|---|---|---|---|---|---|---|
| Cortical Patches | 0 | 0 | 0 | 0 | 0 | 0 | 0 | 0 | 0 | 0 | 0 | 0 | 0 | 0 | 0 |
| Bud | 0 | 0 | 0 | 0 | 0 | 0 | 0 | 0 | 0 | 0 | 0 | 0 | 0 | 0 | 0 |
| Bud Neck | 0 | 0 | 0 | 0 | 0 | 0 | 0 | 0 | 0 | 0 | 0 | 0 | 0 | 0 | 0 |
| Bud Site | 0 | 0 | 0 | 0 | 0 | 0 | 0 | 0 | 0 | 0 | 0 | 0 | 0 | 0 | 0 |
| Cell Periphery | 0 | 0 | 0 | 0 | 0 | 0 | 0 | 0 | 0 | 0 | 0 | 0 | 0 | 0 | 0 |
| Cytoplasm | -0.3 | -1.0 | -2.8 | -3.2 | -3.5 | -3.9 | -4.5 | -3.3 | -4.1 | 0.6 | 1.6 | 1.2 | -1.4 | -1.9 | -1.0 |
| Endoplasmic Reticulum | 0 | 0 | 0 | 0 | 0 | 0 | 0 | 0 | 0 | 0 | 0 | 0 | 0 | 0 | 0 |
| Endosome | 0 | 0 | 0 | 0 | 0 | 0 | 0 | 0 | 0 | 0 | 0 | 0 | 0 | 0 | 0 |
| Golgi | 0 | 0 | 0 | 0 | 0 | 0 | 0 | 0 | 0 | 0 | 0 | 0 | 0 | 0 | 0 |
| Mitochondria | 0 | 0 | 0 | 0 | 0 | 2.9 | 0 | 3.0 | 0 | 0 | 0 | 0 | 0 | 0 | 0 |
| Nucleus | 0 | 0 | 0 | 0 | 0 | 0 | 0 | 0 | 0 | 0 | 0 | 0 | 0 | 0 | 0 |
| Nuclear Periphery | 0 | 0 | 0 | 0 | 0 | 0 | 0 | 0 | 0 | 0 | 0 | 0 | 0 | 0 | 0 |
| Nucleolus | 0 | 0 | 0 | 0 | 0 | 0 | 0 | 0 | 0 | 0 | 0 | 0 | 0 | 0 | 0 |
| Peroxisomes | 0 | 0 | 0 | 0 | 0 | 0 | 0 | 0 | 0 | 0 | 0 | 0 | 0 | 0 | 0 |
| SpindlePole | 0 | 0 | 0 | 0 | 0 | 0 | 0 | 0 | 0 | 0 | 0 | 0 | 0 | 0 | 0 |
| Vacuole | 0 | 0 | 3.2 | 3.3 | 2.9 | 0 | 3.9 | 0 | 3.1 | 0 | 0 | 0 | 0 | 0 | 0 |
External localization resources
Images






























Protein Concentration and Protein Localization Data
| R1 | R2 | R3 | ||||||||||||||||
|---|---|---|---|---|---|---|---|---|---|---|---|---|---|---|---|---|---|---|
| G1 Pre-START | G1 Post-START | S/G2 | Metaphase | Anaphase | Telophase | G1 Pre-START | G1 Post-START | S/G2 | Metaphase | Anaphase | Telophase | G1 Pre-START | G1 Post-START | S/G2 | Metaphase | Anaphase | Telophase | |
| Concentration | 2.6176 | 3.7845 | 3.2683 | 2.745 | 2.1594 | 3.144 | 3.0119 | 4.2847 | 4.274 | 3.6857 | 2.3314 | 3.9778 | 1.9285 | 3.625 | 2.9482 | 2.9158 | 2.5612 | 3.0709 |
| Actin | 0.0226 | 0.0039 | 0.0079 | 0.0071 | 0.003 | 0.0067 | 0.0196 | 0.0006 | 0.0071 | 0.0003 | 0.0152 | 0.0008 | 0.0259 | 0.0058 | 0.0089 | 0.0003 | 0.003 | 0.0007 |
| Bud | 0.0084 | 0.0117 | 0.0126 | 0.0056 | 0.0329 | 0.0055 | 0.0006 | 0.0011 | 0.0011 | 0.0001 | 0.0038 | 0.0001 | 0.002 | 0.005 | 0.003 | 0.0002 | 0.001 | 0.0001 |
| Bud Neck | 0.0021 | 0.0013 | 0.0011 | 0.0013 | 0.0006 | 0.0072 | 0.002 | 0.0001 | 0.0003 | 0.0003 | 0.0022 | 0.0009 | 0.0035 | 0.0004 | 0.0005 | 0.0003 | 0.0008 | 0.0009 |
| Bud Periphery | 0.0043 | 0.0029 | 0.0067 | 0.0022 | 0.0356 | 0.0029 | 0.0006 | 0.001 | 0.0025 | 0 | 0.007 | 0 | 0.0013 | 0.0013 | 0.0012 | 0.0001 | 0.0023 | 0.0001 |
| Bud Site | 0.0061 | 0.017 | 0.0104 | 0.0021 | 0.0009 | 0.001 | 0.0071 | 0.0009 | 0.0034 | 0.0001 | 0.0045 | 0.0001 | 0.005 | 0.0095 | 0.0038 | 0.0001 | 0.0031 | 0.0001 |
| Cell Periphery | 0.0004 | 0.0002 | 0.0003 | 0.0002 | 0.0002 | 0.0001 | 0.0003 | 0 | 0.0003 | 0 | 0.0003 | 0 | 0.0003 | 0.0004 | 0.0001 | 0 | 0.0001 | 0 |
| Cytoplasm | 0.7587 | 0.854 | 0.7299 | 0.8304 | 0.7452 | 0.8289 | 0.7451 | 0.9386 | 0.8976 | 0.9828 | 0.8603 | 0.9456 | 0.8536 | 0.9293 | 0.895 | 0.936 | 0.9005 | 0.9497 |
| Cytoplasmic Foci | 0.0178 | 0.0089 | 0.0163 | 0.018 | 0.0248 | 0.0193 | 0.0364 | 0.0096 | 0.01 | 0.0018 | 0.015 | 0.0116 | 0.0222 | 0.0044 | 0.0103 | 0.0139 | 0.0039 | 0.0043 |
| Eisosomes | 0.0005 | 0 | 0.0001 | 0 | 0 | 0.0001 | 0.0003 | 0 | 0.0001 | 0 | 0.0001 | 0 | 0.0004 | 0.0009 | 0.0001 | 0 | 0.0001 | 0 |
| Endoplasmic Reticulum | 0.0054 | 0.0015 | 0.004 | 0.0055 | 0.0011 | 0.0023 | 0.0033 | 0.0011 | 0.0017 | 0.0008 | 0.0024 | 0.0015 | 0.0031 | 0.0016 | 0.0021 | 0.0025 | 0.0029 | 0.0019 |
| Endosome | 0.0084 | 0.0023 | 0.0126 | 0.0063 | 0.003 | 0.0063 | 0.0227 | 0.0018 | 0.0102 | 0.0004 | 0.0281 | 0.0078 | 0.014 | 0.0016 | 0.005 | 0.0233 | 0.0129 | 0.0037 |
| Golgi | 0.002 | 0.0003 | 0.0016 | 0.0006 | 0.0011 | 0.0006 | 0.0065 | 0.0003 | 0.0046 | 0 | 0.0196 | 0.0032 | 0.0048 | 0.0002 | 0.0029 | 0.0007 | 0.0014 | 0.0004 |
| Lipid Particles | 0.0018 | 0.0001 | 0.0007 | 0.0005 | 0.0003 | 0.0015 | 0.0111 | 0.0001 | 0.0039 | 0 | 0.0029 | 0.0028 | 0.0059 | 0.0002 | 0.0053 | 0.0002 | 0.003 | 0.0006 |
| Mitochondria | 0.0029 | 0.0005 | 0.0028 | 0.0006 | 0.0005 | 0.001 | 0.0131 | 0.0002 | 0.0072 | 0.0001 | 0.0129 | 0.0003 | 0.0035 | 0.0021 | 0.0099 | 0.0002 | 0.0042 | 0.0007 |
| None | 0.1169 | 0.0694 | 0.1439 | 0.058 | 0.1154 | 0.0692 | 0.0919 | 0.0398 | 0.0296 | 0.0081 | 0.0081 | 0.0079 | 0.034 | 0.0304 | 0.0306 | 0.0119 | 0.0307 | 0.0212 |
| Nuclear Periphery | 0.0074 | 0.0017 | 0.0074 | 0.0063 | 0.001 | 0.0026 | 0.0035 | 0.0005 | 0.0008 | 0.0006 | 0.0016 | 0.0013 | 0.0023 | 0.001 | 0.0039 | 0.0019 | 0.0086 | 0.0039 |
| Nucleolus | 0.0055 | 0.0002 | 0.0009 | 0.0005 | 0.0001 | 0.0006 | 0.002 | 0 | 0.0001 | 0 | 0.0003 | 0 | 0.0003 | 0.0002 | 0.0003 | 0 | 0.0008 | 0.0004 |
| Nucleus | 0.0162 | 0.017 | 0.0272 | 0.0219 | 0.0071 | 0.0226 | 0.0054 | 0.0026 | 0.0031 | 0.004 | 0.0042 | 0.0102 | 0.0046 | 0.004 | 0.005 | 0.0061 | 0.0109 | 0.0085 |
| Peroxisomes | 0.0026 | 0.0012 | 0.0009 | 0.0007 | 0.0246 | 0.0021 | 0.0154 | 0.0003 | 0.0129 | 0 | 0.0041 | 0.0037 | 0.0096 | 0.0002 | 0.0094 | 0.0002 | 0.0015 | 0.0001 |
| Punctate Nuclear | 0.0065 | 0.0046 | 0.0102 | 0.0296 | 0.0018 | 0.0181 | 0.0098 | 0.0007 | 0.0004 | 0.0003 | 0.0009 | 0.0015 | 0.0013 | 0.0008 | 0.0016 | 0.0007 | 0.0017 | 0.0012 |
| Vacuole | 0.0026 | 0.0012 | 0.002 | 0.0022 | 0.0007 | 0.0011 | 0.0026 | 0.0006 | 0.0023 | 0.0002 | 0.0051 | 0.0006 | 0.0018 | 0.0007 | 0.0008 | 0.001 | 0.0043 | 0.0009 |
| Vacuole Periphery | 0.0007 | 0.0002 | 0.0007 | 0.0005 | 0.0001 | 0.0003 | 0.0006 | 0.0001 | 0.001 | 0 | 0.0014 | 0.0001 | 0.0005 | 0.0001 | 0.0003 | 0.0003 | 0.0021 | 0.0005 |
Sequencing Data
| R1 | R2 | |||||||||
|---|---|---|---|---|---|---|---|---|---|---|
| G1 Post-START | S/G2 | Metaphase | Anaphase | Telophase | G1 Post-START | S/G2 | Metaphase | Anaphase | Telophase | |
| Gene Expression | 55.8969 | 84.9463 | 53.3933 | 47.5568 | 46.3826 | 65.9218 | 64.6694 | 44.6705 | 49.1272 | 47.5481 |
| Translational Efficiency | 1.804 | 1.7303 | 1.4688 | 1.6238 | 1.6402 | 1.382 | 1.6026 | 1.6976 | 1.5114 | 1.2213 |
Hit Data
| Dataset | Hit |
|---|---|
| Protein Concentration | ✘ |
| Protein Localization | ✘ |
| Gene Expression | ✔ |
| Translational Efficiency | ✘ |
Endocytosis
| Temp | Actin Patch (Sac6-tdTomato) | Cortical Patch (Sla1-GFP) | Late Endosome (Snf7-GFP) | Vacuole (Vph1-GFP) |
|---|---|---|---|---|
| 37℃ | ||||
| RT |
Cell Cycle Omics
CYCLoPs (Hem13-GFP)
| Gene / Allele | Actin Patch (Sac6-tdTomato) | Cortical Patch (Sla1-GFP) | Late Endosome (Snf7-GFP) | Vacuole (Sac6-tdTomato) |
|---|
| Gene | Images |
|---|
| Gene | Images |
|---|
Images are not yet available
Images are not yet available